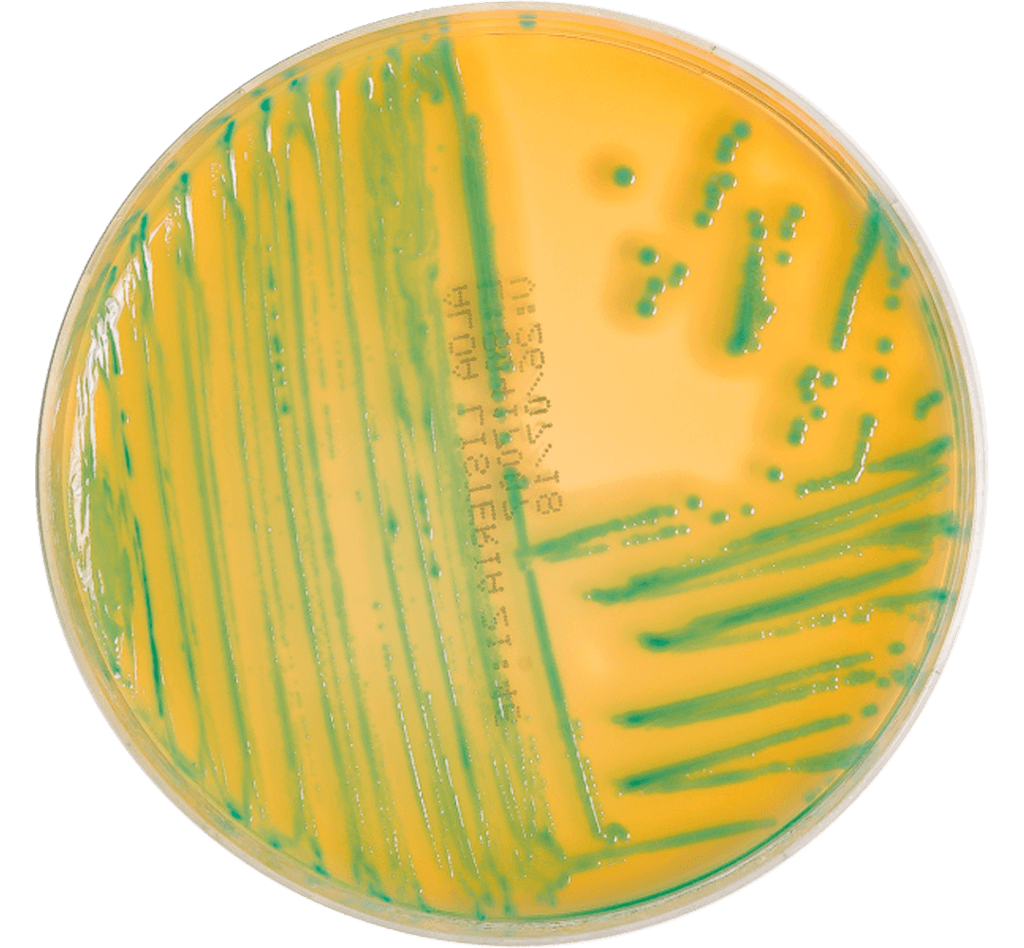

O Listeria ALOA Ágar é um meio de cultura cromogênico específico para o isolamento e identificação de Listeria monocytogenes e Listeria spp. em alimentos e amostras ambientais, seguindo a norma ISO 11290, que descreve métodos de cultivo para o isolamento e diferenciação desse microrganismo. Esse meio contém substratos específicos que permitem a diferenciação de L. monocytogenes das outras espécies de Listeria com base na cor das colônias, facilitando a detecção e a diferenciação rápida.